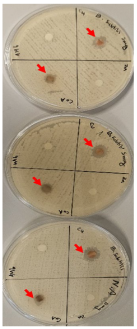
Ijms 26 10516 i027 Ijms 26 10516 i027

Significance of Nano Transition Metal Complexes as Anticancer and Antibacterial Therapeutic Agents
Abstract
1. Introduction
2. Results
2.1. Elemental Analysis, Electronic Spectra, and Magnetic and Physical Measurements
2.2. Mass Spectra of Metal–Ligand Complexes (MS)
2.3. Nuclear Magnetic Resonance (1H and 13C)
2.4. Infrared (FTIR) Spectra of Co, Cu, and Zn Complexes
- i.
- The negative shift in position (4–30 cm−1) and intensity of the band of the imine group C=N) [56].
- ii.
- The displacement of the imine group ν(N-H6,7) band upon chelation, signifying that the thiosemicarbazone in these complexes interacted in the thioenol form, that was endorsed by the appearance of a new band in the 1640–1690 cm−1 region, assignable to ν(C=N-N=C) [56].
- iii.
- iv.
- The appearance of new bands at 451–476 and 497–519 cm−1, which could be attributed to ν(M-S) and ν(M ← N), respectively [58].
2.5. Thermal Gravimetric Analysis (TGA)
2.6. Differential Scanning Calorimetry (DSC) Characterization
2.7. Investigation of the Complexes’ Morphology by SEM
2.8. Particle Size Measurements of Metal–Ligand Complexes by DSC
2.9. Cell Proliferation Assessments
2.10. Computational Analysis of Optimized Geometry and Energy Gap
2.11. Antibacterial Evaluation
3. Discussion
4. Materials and Methods
4.1. Materials and Reagents
4.2. Instruments Used
4.3. Synthesis
4.3.1. General Synthesis of the Ligand: 2,2′-(butane-2,3-diylidene) Bis(hydrazine-1-carbothioamide)
4.3.2. General Synthesis of the Metal–Ligand Complex
4.4. Generating Thermal Gravimetric Curves (TGA)
4.5. Differential Scanning Calorimetry Technique (DSC)
4.6. Investigating the Complexes’ Morphology by SEM
4.7. Particle Size Measurements by DLS
4.8. Cytotoxicity Assessment and Statistical Analysis
4.9. Molecular Geometry and Computational Methodology
4.10. In Vitro Antibacterial Activity
5. Conclusions
Author Contributions
Funding
Institutional Review Board Statement
Informed Consent Statement
Data Availability Statement
Acknowledgments
Conflicts of Interest
References
- Shazia, R.; Muhammad, I.; Anwar, N.; Haji, A.; Amin, A. Transition metal complexes as potential therapeutic agents. Biotechnol. Mol. Biol. Rev. 2010, 5, 38–45. [Google Scholar]
- Karges, J.; Stokesm, R.W.; Cohen, S.M. Metal Complexes for Therapeutic Applications. Trends Chem. 2021, 3, 523–534. [Google Scholar] [CrossRef] [PubMed]
- Klaudia, J.; Marianna, M.; Suliman, Y.; Saleh, H.A.; Eugenie, N.; Kamil, K.; Christopher, J.R.; Marian, V. Essential metals in health and disease. Chem.-Biol. Interact. 2022, 367, 110173. [Google Scholar]
- Church, D.L. Major factors affecting the emergence and re-emergence of infectious diseases. Clin. Lab. Med. 2004, 24, 559–586. [Google Scholar] [CrossRef]
- Van, C.R.; van de Vijver, S.; Moore, D.A.J. The global diabetes epidemic: What does it mean for infectious diseases in tropical countries? Lancet Diabetes Endocrinol. 2017, 5, 457–468. [Google Scholar] [CrossRef]
- Ellis, T.; Eze, E.; Raimi-Abraham, B.T. Malaria and Cancer: A critical review on the established associations and new perspectives. Infect. Agents Cancer 2021, 16, 33. [Google Scholar] [CrossRef]
- Liu, Q.; Jing, W.; Kang, L.; Liu, J.; Liu, M. Trends of the global, regional and national incidence of malaria in 204 countries from 1990 to 2019 and implications for malaria prevention. J. Travel Med. 2021, 28, taab046. [Google Scholar] [CrossRef]
- Byrne, C.; Divekar, S.D.; Storchan, G.B.; Parodi, D.A.; Martin, M.B. Metals and Breast Cancer. J. Mammary Gland Biol. Neoplasia 2013, 18, 63–73. [Google Scholar] [CrossRef]
- Maret, W. The Metals in the Biological Periodic System of the Elements: Concepts and Conjectures. Int. J. Mol. Sci. 2016, 17, 66. [Google Scholar] [CrossRef]
- Maria, A.; Zoroddu, J.A.; Guido, C.; Serenella, M.; Massimiliano, P.; Valeria, M.N. The essential metals for humans: A brief overview. J. Inorg. Biochem. 2019, 195, 120–129. [Google Scholar] [CrossRef]
- Ejaz, H.W.; Wang, W.; Lang, M. Copper Toxicity Links to Pathogenesis of Alzheimer’s Disease and Therapeutics Approaches. Int. J. Mol. Sci. 2020, 21, 7660. [Google Scholar] [CrossRef]
- Pradhan, S.H.; Liu, J.Y.; Sayes, C.M. Evaluating Manganese, Zinc, and Copper Metal Toxicity on SH-SY5Y Cells in Establishing an Idiopathic Parkinson’s Disease Model. Int. J. Mol. Sci. 2023, 24, 16129. [Google Scholar] [CrossRef]
- Houtman, J.P. Trace elements and cardiovascular diseases. J. Cardiovasc. Risk 1996, 3, 18–25. [Google Scholar] [CrossRef] [PubMed]
- Górska, A.; Markiewicz-Gospodarek, A.; Trubalski, M.; Żerebiec, M.; Poleszak, J.; Markiewicz, R. Assessment of the Impact of Trace Essential Metals on Cancer Development. Int. J. Mol. Sci. 2024, 25, 6842. [Google Scholar] [CrossRef] [PubMed]
- Bjørklund, G.; Dadar, M.; Pivina, L.; Doşa, M.D.; Semenova, Y.; Aaseth, J. The Role of Zinc and Copper in Insulin Resistance and Diabetes Mellitus. Curr. Med. Chem. 2020, 27, 6643–6657. [Google Scholar] [CrossRef] [PubMed]
- Raczuk, E.; Dmochowska, B.; Samaszko-Fiertek, J.; Madaj, J. Different Schiff Bases-Structure, Importance and Classification. Molecules 2022, 27, 787. [Google Scholar] [CrossRef]
- Mohamed, A.A.; El-Gedamy, M.S.; Sadeek, S.A.; Elshafie, H.S. First Report on some N2O2-Donor Sets Tetradentate Schiff Base and Its Metal Complexes: Characterization and Antimicrobial Investigation. Chem. Biodivers. 2025, e01117. [Google Scholar] [CrossRef]
- Elshafie, H.S.; Sadeek, S.A.; Camele, I.; Mohamed, A.A. Biochemical Characterization of New Gemifloxacin Schiff Base (GMFX-o-phdn) Metal Complexes and Evaluation of Their Antimicrobial Activity against Some Phyto- or Human Pathogens. Int. J. Mol. Sci. 2022, 23, 2110. [Google Scholar] [CrossRef]
- Mohamed, A.A.; Ahmed, F.M.; Zordok, W.A.; El-Shwiniy, W.H.; Sadeek, S.A.; Elshafie, H.S. Novel Enrofloxacin Schiff Base Metal Complexes: Synthesis, Spectroscopic Characterization, Computational Simulation and Antimicrobial Investigation against Some Food and Phyto-Pathogens. Inorganics 2022, 10, 177. [Google Scholar] [CrossRef]
- Sousa, C.; Freire, C.; De Castro, B. Synthesis and Characterization of Benzo-15-Crown-5 Ethers with Appended N2O Schiff Bases. Molecules 2003, 8, 894–900. [Google Scholar] [CrossRef]
- Yildirm, L.T.; Atakol, O. Crystal structure analysis of Bis{(N,N′-dimethylformamide)-[μ-bis-N,N′-(2-oxybenzyl)-1,3-propanediaminato](μ-asetato) nickel(II)}nickel(II). Cryst. Res. Technol. 2002, 37, 1352–1359. [Google Scholar] [CrossRef]
- Tesauro, D. Metal Complexes in Diagnosis and Therapy. Int. J. Mol. Sci. 2022, 23, 4377. [Google Scholar] [CrossRef]
- Hapke, M.; Hilt, G. Introduction to cobalt chemistry and catalysis. In Cobalt Catalysis in Organic Synthesis: Methods and Reactions; Wiley: Hoboken, NJ, USA, 2020; pp. 1–23. [Google Scholar]
- Valko, M.; Klement, R.; Pelikan, P.; Boca, R.; Dlhan, L.; Bottcher, A.; Elias, H.; Muller, L. Copper (II) and Cobalt (II) complexes with derivatives of Salen and Tetrahydrosalen: An electron spin resonance, magnetic susceptibility, and quantum chemical study. J. Phys. Chem. 1995, 99, 137–143. [Google Scholar] [CrossRef]
- Chang, E.L.; Simmers, C.; Knight, D.A. Cobalt Complexes as Antiviral and Antibacterial Agents. Pharmaceuticals 2010, 3, 1711–1728. [Google Scholar] [CrossRef] [PubMed]
- Sopbué, F.E.; Songmi, F.S.; Tamokou, J.d.D.; Tsopmo, A.; Doungmo, G.; Wilhelm, P.S.F.; Tsamo, D.L.F.; Ndjakou, P.L.; Kuiate, J.R. Synthesis, characterization, and antibacterial activity studies of two Co(II) complexes with 2-[(E)-(3-acetyl-4-hydroxyphenyl)diazenyl]-4-(2-hydroxyphenyl)thiophene-3-carboxylic acid as a ligand. BMC Chem. 2024, 18, 75. [Google Scholar]
- Kamalakannan, P.; Venkappayya, D. Synthesis and characterization of cobalt and nickel chelates of 5-dimethylaminomethyl-2-thiouracil and their evaluation as antimicrobial and anticancer agents. J. Inorg. Biochem. 2002, 90, 22–37. [Google Scholar] [CrossRef]
- Kaim, W.; Schwederski, B. Bioinorganic Chemistry: Inorganic Elements in the Chemistry of Life; Wiley: Hoboken, NJ, USA, 1994; pp. 1–432. [Google Scholar]
- Lippard, S.J.; Berg, J.M. Principles of Bioinorganic Chemistry; University Science Books: Mill Valley, CA, USA, 1994; pp. 1–411. [Google Scholar]
- Virag, L.; Erdodi, F.; Gergely, P. Bioinorganic Chemistry for Medical Students; University of Debrecen: Debrecen, Hungary, 2016; pp. 1–104. [Google Scholar]
- Simunkova, M.; Lauro, P.; Jomova, K.; Hudecova, L.; Danko, M.; Alwasel, S.; Alhazza, I.M.; Rajcaniova, S.; Kozovska, Z.; Kucerova, L.; et al. Redox-cycling and intercalating properties of novel mixed copper (II) complexes with non-steroidal anti-inflammatory drugs tolfenamic, mefenamic and flufenamic acids and phenanthroline functionality: Structure, SOD-mimetic activity, interaction with albumin, DNA damage study and anticancer activity. J. Inorg. Biochem. 2019, 194, 97–113. [Google Scholar]
- Olar, R.; Badea, M.; Bacalum, M.; Răileanu, M.; Ruţă, L.L.; Farcaşanu, I.C.; Rostas, A.M.; Vlaicu, I.D.; Popa, M.; Chifiriuc, M.C. Antiproliferative and antibacterial properties of biocompatible copper (II) complexes bearing chelating N,N-heterocycle ligands and potential mechanisms of action. Biometals 2021, 34, 1155–1172. [Google Scholar] [CrossRef]
- Villarreal, W.; Castro, W.; González, S.; Madamet, M.; Amalvict, R.; Pradines, B.; Navarro, M. Copper (I)-Chloroquine Complexes: Interactions with DNA and Ferriprotoporphyrin, Inhibition of β-Hematin Formation and Relation to Antimalarial Activity. Pharmaceuticals 2022, 15, 921. [Google Scholar] [CrossRef]
- Benters, J.; Flogel, U.; Schafer, T.; Leibfritz, D.; Hechtenberg, S.; Beyersmann, D. Study of the interactions of cadmium and zinc ions with cellular alcium homoeostasis using 19F-NMR spectroscopy. Biochem. J. 1997, 322, 793–799. [Google Scholar] [CrossRef]
- Ye, R.; Tan, C.; Chen, B.; Li, R.; Mao, Z. Zinc-Containing Metalloenzymes: Inhibition by Metal-Based Anticancer Agents. Front. Chem. 2020, 8, 402. [Google Scholar] [CrossRef]
- Klug, A.; Rhodes, D. Zinc fingers: A novel protein fold for nucleic acid recognition. Cold Spring Harbor Symp. Quant. Biol. 1987, 52, 473–482. [Google Scholar] [CrossRef] [PubMed]
- Mousa, A.B.; Moawad, R.; Abdallah, Y.; Abdel-Rasheed, M.; Abdel Zaher, A.M. Zinc Oxide Nanoparticles Promise Anticancer and Antibacterial Activity in Ovarian Cancer. Pharm. Res. 2023, 40, 2281–2290. [Google Scholar] [CrossRef] [PubMed]
- Khashan, K.S.; Sulaiman, G.M.; Hussain, S.A.; Marzoog, T.R.; Jabir, M.S. Synthesis, Characterization and Evaluation of Anti-bacterial, Anti-parasitic and Anti-cancer Activities of Aluminum-Doped Zinc Oxide Nanoparticles. J. Inorg. Organomet. Polym. Mater. 2020, 30, 3677–3693. [Google Scholar] [CrossRef]
- Bai, X.G.; Zheng, Y.; Qi, J. Advances in thiosemicarbazone metal complexes as anti-lung cancer agents. Front. Pharmacol. 2022, 13, 1018951. [Google Scholar] [CrossRef]
- Serda, M.; Kalinowski, D.S.; Rasko, N.; Potůčková, E.; Mrozek-Wilczkiewicz, A.; Musiol, R.; Małecki, J.G.; Sajewicz, M.; Ratuszna, A.; Muchowicz, A.; et al. Exploring the anti-cancer activity of novel thiosemicarbazones generated through the combination of retro-fragments: Dissection of critical structure-activity relationships. PLoS ONE 2014, 9, e110291. [Google Scholar] [CrossRef]
- Donmez, M.; Sekerci, M.; Adiguzel, R.; Oğuz, E.; Türkan, F.; Yildiko, U.; Colak, N. Synthesis and characterization of novel bis(thiosemicarbazone) complexes and investigation of their acetylcholinesterase and glutathione S-transferase activities with in silico and in vitro studies. Mol. Divers. 2025, 9, 1109–1127. [Google Scholar] [CrossRef]
- Jain, P.; Vishvakarma, V.K.; Singh, P.; Yadav, S.; Kumar, R.; Chandra, S.; Kumar, D.; Misra, N. Bioactive Thiosemicarbazone Coordination Metal Complexes: Synthesis, Characterization, Theoretical analysis, Biological Activity, Molecular Docking and ADME analysis. Chem. Biodivers. 2023, 20, e202300760. [Google Scholar] [CrossRef]
- Şen, B. 2-Acetyl-5-chloro-thiophene thiosemicarbazone and its nickel(II) and zinc(II) complexes: Hirshfeld surface analysis and Density Functional Theory calculations for molecular geometry, vibrational spectra and HOMO-LUMO studies. Turk. Comput. Theor. Chem. 2021, 5, 27–38. [Google Scholar] [CrossRef]
- Gaber, M.; El-Ghamry, H.A.; Mansour, M.A. Pd (II) and Pt (II) chalcone complexes. Synthesis, spectral characterization, molecular modeling, biomolecular docking, antimicrobial and antitumor activities. J. Photochem. Photobiol. A Chem. 2018, 354, 163–174. [Google Scholar] [CrossRef]
- Ilies, D.C.; Pahontu, E.; Shova, S.; Georgescu, R.; Stanica, N.; Olar, R.; Gulea, A.; Rosu, T. Synthesis, characterization, crystal structure and antimicrobial activity of copper (II) complexes with a thiosemicarbazone derived from 3-formyl-6-methylchromone. Polyhedron 2014, 81, 123–131. [Google Scholar] [CrossRef]
- Emam, S.M.; El Sayed, I.E.T.; Ayad, M.I.; Hathout, H.M.R. Synthesis, characterization and anticancer activity of new Schiff bases bearing neocryptolepine. J. Mol. Struct. 2017, 1146, 600–619. [Google Scholar] [CrossRef]
- Chandra, S.; Bargujar, S.; Nirwal, R.; Yadav, N. Synthesis, spectral characterization and biological evaluation of copper(II) and nickel(II) complexes with thiosemicarbazones derived from a bidentate Schiff base. Spectrochim. Acta Part A Mol. Biomol. Spectrosc. 2013, 106, 91–98. [Google Scholar] [CrossRef] [PubMed]
- Saghatforoush, L.A.; Hosseinpour, S.; Bezpalko, M.W.; Kassel, W.S. Synthesis, spectroscopic studies and X-ray structure determination of two mononuclear copper complexes derived from the Schiff base ligand N,N-dimethyl-N′-((5-methyl-1H-imidazol-4-yl)methylene)ethane-1,2-diamine. Inorg. Chim. Acta 2019, 484, 527. [Google Scholar]
- Shahsavani, E.; Khalaji, A.D.; Feizi, N.; Kučeráková, M.; Dušek, M. Synthesis, characterization, crystal structure and antibacterial activity of new sulfur-bridged dinuclear silver(I) thiosemicarbazone complex [Ag2(PPh3)2(μ-S-Brcatsc)2(η1-S-Brcatsc)2](NO3)2. Inorg. Chim. Acta 2015, 429, 61. [Google Scholar] [CrossRef]
- Rageh, N.M.; Mawgoud, A.M.A.; Mostafa, H.M. Transition Metal Complexes Derived From 2-hydroxy-4-(p-tolyldiazenyl)benzylidene)-2-(p-tolylamino)acetohydrazide Synthesis, Structural Characterization, and Biological Activities. Chem. Pap. 1999, 53, 107. [Google Scholar]
- Lever, A.B.P. Inorganic Electronic Spectroscopy; Elsevier: Amsterdam, The Netherlands, 1984; Volume 46. [Google Scholar]
- Chehelgerdi, M.; Chehelgerdi, M.; Allela, O.Q.B.; Pecho, R.D.C.; Jayasankar, N.; Rao, D.P.; Thamaraikani, T.; Vasanthan, M.; Viktor, P.; Lakshmaiya, N.; et al. Progressing nanotechnology to improve targeted cancer treatment: Overcoming hurdles in its clinical implementation. Mol. Cancer 2023, 22, 169. [Google Scholar] [CrossRef]
- Prabhakaran, P.; Hassiotou, F.; Blancafort, P.; Filgueira, L. Cisplatin induces differentiation of breast cancer cells. Front. Oncol. 2013, 3, 134. [Google Scholar] [CrossRef]
- Sethukumar, A.; Udhaya Kumar, C.; Agilandeshwari, R.; Arul Prakasam, B. Synthesis, stereochemical, structural and biological studies of some 2,6-diarylpiperidin-4-one N(4′)-cyclohexyl thiosemicarbazones. J. Mol. Struct. 2013, 1047, 237–248. [Google Scholar] [CrossRef]
- Vijayan, P.; Vijayapritha, S.; Ruba, C.; Viswanathamurthi, P.; Linert, W. Ruthenium(II) carbonyl complexes containing thiourea ligand: Enhancing the biological assets through biomolecules interaction and enzyme mimetic activities. Monatsh Chem. 2019, 150, 1059–1071. [Google Scholar] [CrossRef]
- Şen, B.; Kalhan, H.K.; Demir, V.; Güler, E.E. Crystal structures, spectroscopic properties of new cobalt(II), nickel(II), zinc(II) and palladium(II) complexes derived from 2-acetyl-5-chloro thiophene thiosemicarbazone: Anticancer evaluation. Mater. Sci. Eng. C 2019, 98, 550–559. [Google Scholar] [CrossRef]
- Piri, Z.; Moradi–Shoeili, Z.; Assoud, A. Ultrasonic assisted synthesis, crystallographic, spectroscopic studies and biological activity of three new Zn(II), Co(II) and Ni(II) thiosemicarbazone complexes as precursors for nano-metal oxides. Inorg. Chim. Acta 2019, 484, 338. [Google Scholar] [CrossRef]
- Akbari, A.; Ghateazadeh, H.; Takjoo, R.; Sadeghi-Nejad, B.; Mehrvar, M.; Mague, J.T. Synthesis & crystal structures of four new biochemical active Ni(II) complexes of thiosemicarbazone and isothiosemicarbazone-based ligands: In vitro antimicrobial study. J. Mol. Struct. 2019, 1181, 287. [Google Scholar]
- Mayada, S.A.; Fathy, A.E.; Mohamad, M.E.; Sadashiva, K.; Laila, A.J.A. Synthesis and characterization of thiosemicarbazone metal complexes: Crystal structure, and antiproliferation activity against breast (MCF7) and lung (A549) cancers. J. Mol. Struct. 2023, 1274, 13448. [Google Scholar]
- Ali, M.S.; Kuraijam, D.; Karnik, S.; Jaragh-Alhadad, L.A. Hydrazone bimetallic complex: Synthesis, characterization, in silico and biological evaluation targeting breast and lung cancer cells’ G-quadruplex DNA. Kuwait J. Sci. 2023, 50, 1–17. [Google Scholar] [CrossRef]
- Zhu, W.; Li, Y.; Gao, L. Cisplatin in combination with programmed cell death protein 5 increases antitumor activity in prostate cancer cells by promoting apoptosis. Mol. Med. Rep. 2015, 11, 4561–4566. [Google Scholar] [CrossRef] [PubMed]
- He, Y.; Zhu, Q.; Chen, M.; Huang, Q.; Wang, W.; Li, Q.; Huang, Y.; Di, W. The changing 50% inhibitory concentration (IC50) of cisplatin: A pilot study on the artifacts of the MTT assay and the precise measurement of density-dependent chemoresistance in ovarian cancer. Oncotarget 2016, 7, 70803–70821. [Google Scholar] [CrossRef]
- Ćwiklińska-Jurkowska, M.; Wiese-Szadkowska, M.; Janciauskiene, S.; Paprocka, R. Disparities in Cisplatin-Induced Cytotoxicity—A Meta-Analysis of Selected Cancer Cell Lines. Molecules 2023, 28, 5761. [Google Scholar] [CrossRef]
- Kotova, O.; Lyssenko, K.; Rogachev, A.; Eliseeva, S.; Fedyanin, I.; Lepnev, L.; Pandey, L.; Burlov, A.; Garnovskii, A.; Vitukhnovsky, A.; et al. Low temperature X-ray diffraction analysis, electronic density distribution and photophysical properties of bidentate N,O-donor salicylaldehyde Schiff bases and zinc complexes in solid state. J. Photochem. Photobiol. A Chem 2011, 218, 117–129. [Google Scholar] [CrossRef]
- Chiş, V.; Filip, S.; Miclăuş, V.; Pîrnău, A.; Tănăselia, C.; Almăşan, V.; Vasilescu, M. Vibrational spectroscopy and theoretical studies on 2,4-dinitrophenylhydrazine. J. Mol. Struct. 2005, 744, 363. [Google Scholar] [CrossRef]
- Karabacak, M.; Kose, E.; Atac, A. Molecular structure (monomeric and dimeric structure) and HOMO–LUMO analysis of 2-aminonicotinic acid: A comparison of calculated spectroscopic properties with FT-IR and UV–Vis. Spectrochim. Acta Part A Mol. Biomol. Spectrosc. 2012, 91, 83–96. [Google Scholar] [CrossRef]
- Atac, A.; Karabacak, M.; Karaca, C.; Kose, E. NMR, UV, FT-IR, FT-Raman spectra and molecular structure (monomeric and dimeric structures) investigation of nicotinic acid N-oxide: A combined experimental and theoretical study. Spectrochim. Acta Part A Mol. Biomol. Spectrosc. 2012, 85, 145–154. [Google Scholar] [CrossRef]
- Porchelvi, E.E.; Muthu, S. Vibrational spectra, molecular structure, natural bond orbital, first order hyperpolarizability, thermodynamic analysis and normal coordinate analysis of Salicylaldehyde p-methylphenylthiosemicarbazone by density functional method. Spectrochim. Acta Part A Mol. Biomol. Spectrosc. 2015, 134, 453–464. [Google Scholar] [CrossRef] [PubMed]
- Mayada, S.A.; Mohamad, H. Chelating activity of (2E,2′E)-2,2′-(pyridine-2,6-diylbis(ethan-1-yl-1-ylidene)bis(N-ethylhydrazinecarbothioamide). J. Mol. Struct. 2021, 1238, 130436. [Google Scholar] [CrossRef]
- Damena, T.; Zeleke, D.; Desalegn, T.; Demissie, T.B.; Eswaramoorthy, R. Synthesis, Characterization, and Biological Activities of Novel Vanadium(IV) and Cobalt(II) Complexes. ACS Omega 2022, 7, 4389–4404. [Google Scholar] [CrossRef] [PubMed]
- Hasan, M.M.; Ahsan, H.M.; Saha, P.; Naime, J.; Kumar Das, A. Antioxidant, Antibacterial and Electrochemical Activity of (E)-N-(4 (Dimethylamino) Benzylidene)-4H-1,2,4-Triazol-4-Amine Ligand and Its Transition Metal Complexes. Results Chem. 2021, 3, 00115. [Google Scholar] [CrossRef]
- Chebout, O.; Trifa, C.; Bouacida, S.; Boudraa, M.; Imane, H. Two New Copper (II) Complexes with Sulfanilamide as Ligand: Synthesis, Structural, Thermal Analysis, Electrochemical Studies and Antibacterial Activity. J. Mol. Struct. 2022, 1248, 131446. [Google Scholar] [CrossRef]
- Balouiri, M.; Sadiki, M.; Ibnsouda, S.K. Methods for invitro evaluating antimicrobial activity: A review. J. Pharm. Anal. 2015, 6, 71–79. [Google Scholar] [CrossRef]
- Jaragh-Alhadada, L.; Behbehania, H.; Karnik, S. Cancer targeted drug delivery using active low-density lipoprotein nanoparticles encapsulated pyrimidines heterocyclic anticancer agents as microtubule inhibitors. Drug Deliv. 2022, 29, 2759–2772. [Google Scholar] [CrossRef]
- Laila, A.J.A.; Mayada, S.A.; Moustafa, S.M.; Gamaleldin, I.H.; Fars, K.A.; Sadashiva, K. Sulfonamide derivatives mediate breast and lung cancer cell line killing through tubulin inhibition. J. Mol. Struct. 2022, 1268, 133699. [Google Scholar] [CrossRef]
- Jaragh-Alhadad, L.; Samir, M.; Harford, T.J.; Karnik, S. Low-density lipoprotein encapsulated thiosemicarbazone metal complexes is active targeting vehicle for breast, lung, and prostate cancers. Drug Deliv. 2022, 29, 2206–2216. [Google Scholar] [CrossRef]
- Hembram, K.C.; Kumar, R.; Kandha, L.; Parhi, P.K.; Kundu, C.N.; Bindhani, B.K. Therapeutic prospective of plant-induced silver nanoparticles: Application as antimicrobial and anticancer agent. Artif. Cells Nanomed. Biotechnol. 2018, 46 (Suppl. 3), S38–S51. [Google Scholar] [CrossRef]
- Bisht, G.; Rayamajhi, S. ZnO Nanoparticles: A Promising Anticancer Agent. Nanobiomedicine 2016, 3, 9. [Google Scholar] [CrossRef] [PubMed]
- Arshad, F.; Naikoo, G.A.; Hassan, I.U.; Chava, S.R.; El-Tanani, M.; Aljabali, A.A.; Tambuwala, M.M. Bioinspired and Green Synthesis of Silver Nanoparticles for Medical Applications: A Green Perspective. Appl. Biochem. Biotechnol. 2024, 196, 3636–3669. [Google Scholar] [CrossRef] [PubMed]
- Jaragh-Alhadad, L.A.; Falahati, M. Tin oxide nanoparticles trigger the formation of amyloid β oligomers/protofibrils and underlying neurotoxicity as a marker of Alzheimer’s diseases. Int. J. Biol. Macromol. 2022, 204, 154–160. [Google Scholar] [CrossRef] [PubMed]
- Jaragh-Alhadad, L.A.; Falahati, M. Copper oxide nanoparticles promote amyloid-β-triggered neurotoxicity through formation of oligomeric species as a prelude to Alzheimer’s diseases. Int. J. Biol. Macromol. 2022, 207, 121–129. [Google Scholar] [CrossRef]
- Hoshyar, N.; Gray, S.; Han, H.; Bao, G. The effect of nanoparticle size on in vivo pharmacokinetics and cellular interaction. Nanomedicine 2016, 11, 673–692. [Google Scholar] [CrossRef]
- Ejigah, V.; Owoseni, O.; Bataille-Backer, P.; Ogundipe, O.D.; Fisusi, F.A.; Adesina, S.K. Approaches to Improve Macromolecule and Nanoparticle Accumulation in the Tumor Microenvironment by the Enhanced Permeability and Retention Effect. Polymers 2022, 14, 2601. [Google Scholar] [CrossRef]
- Rümenapp, C.; Gleich, B.; Haase, A. Magnetic Nanoparticles in Magnetic Resonance Imaging and Diagnostics. Pharm. Res. 2012, 29, 1165–1179. [Google Scholar] [CrossRef]
- Hoda, F.E.; Saif, M.; Mashaly, M.; Shimaa, A.; Mohamed, F.E.; Eid, M.F.; Nabeel, A.I.; Fouad, R. New nano-complexes of Zn(II), Cu(II), Ni(II) and Co(II) ions; spectroscopy, thermal, structural analysis, DFT calculations and antimicrobial activity application. J. Mol. Struct. 2017, 1147, 452–461. [Google Scholar]
- Sakthivel, A.; Thangagiri, B.; Raman, N.; Joseph, J.; Guda, R.; Kasula, M.; Mitu, L. Spectroscopic, SOD, anticancer, antimicrobial, molecular docking and DNA binding properties of bioactive VO(IV), Cu(II), Zn(II), Co(II), Mn(II) and Ni(II) complexes obtained from 3-(2-hydroxy-3-methoxybenzylidene)pentane-2,4-dione. J. Biomol. Struct. Dyn. 2021, 39, 6500–6514. [Google Scholar] [CrossRef]
- Jain, S.; Rana, M.; Sultana, R.; Mehandi, R.; Rahisuddin. Schiff Base Metal Complexes as Antimicrobial and Anticancer Agents. Polycycl. Aromat. Compd. 2022, 43, 6351–6406. [Google Scholar] [CrossRef]
- Jan, A.T.; Azam, M.; Siddiqui, K.; Ali, A.; Choi, I.; Haq, Q.M.R. Heavy Metals and Human Health: Mechanistic Insight into Toxicity and Counter Defense System of Antioxidants. Int. J. Mol. Sci. 2015, 16, 29592–29630. [Google Scholar] [CrossRef] [PubMed]
- Jaishankar, M.; Tseten, T.; Anbalagan, N.; Mathew, B.B.; Beeregowda, K.N. Toxicity, mechanism and health effects of some heavy metals. Interdiscip. Toxicol. 2014, 7, 60–72. [Google Scholar] [CrossRef] [PubMed]
- Jungwirth, U.; Kowol, C.R.; Keppler, B.K.; Hartinger, C.G.; Berger, W.; Heffeter, P. Anticancer activity of metal complexes: Involvement of redox processes. Antioxid. Redox Signal. 2011, 15, 1085–1127. [Google Scholar] [CrossRef]
- Gai, S.; He, L.; He, M.; Zhong, X. Anticancer Activity and Mode of Action of Cu(II), Zn(II), and Mn(II) Complexes with 5-Chloro-2-N-(2-quinolylmethylene)aminophenol. Molecules 2023, 28, 4876. [Google Scholar] [CrossRef]
- Akl, M.A.; Mostafa, A.G.; El-Zeny, A.S.; El-Gharkawy, E.R.H. Design, spectroscopic analysis, DFT calculations, adsorption evaluation, molecular docking, comprehensive in silico and in vitro bioactivity studies of thiocarbohydrazide grafted dialdehyde cellulose nanobiosorbent. Sci. Rep. 2025, 15, 13319. [Google Scholar] [CrossRef]
- Salehi, R.; Abyar, S.; Ramazani, F.; Khandar, A.K.; Hosseini-Yazdi, S.A.; White, J.M.; Edalati, M.; Kahroba, H.; Talebi, M. Enhanced anticancer potency with reduced nephrotoxicity of newly synthesized platin-based complexes compared with cisplatin. Sci. Rep. 2022, 12, 8316. [Google Scholar] [CrossRef]
- Liang, W.; Huang, Y.; Wang, Y.; Lu, D.; Sun, Q. Research Progress of Platinum-Based Complexes in Lung Cancer Treatment: Mechanisms, Applications, and Challenges. Int. J. Mol. Sci. 2025, 26, 7958. [Google Scholar] [CrossRef]
- Ndagi, U.; Mhlongo, N.; Soliman, M.E. Metal complexes in cancer therapy—An update from drug design perspective. Drug Des. Dev. Ther. 2017, 11, 599–616. [Google Scholar] [CrossRef]
- Howsaui, H.B.; Sharfalddin, A.A.; Abdellattif, M.H.; Basaleh, A.S.; Hussien, M.A. Synthesis, Spectroscopic Characterization and Biological Studies of Mn(II), Cu(II), Ni(II), Co(II) and Zn(II) Complexes with New Schiff Base of 2-((Pyrazine-2-ylimino)methyl)phenol. Appl. Sci. 2021, 11, 9067. [Google Scholar] [CrossRef]
- Ngece, K.; Khwaza, V.; Paca, A.M.; Aderibigbe, B.A. The Antimicrobial Efficacy of Copper Complexes: A Review. Antibiotics 2025, 14, 516. [Google Scholar] [CrossRef]
- Jaragh-Alhadad, L.A.; Ali, M.S. Methoxybenzamide derivative of nimesulide from anti-fever to anti-cancer: Chemical characterization and cytotoxicity. Saudi Pharm. J. 2022, 30, 485–493. [Google Scholar] [CrossRef]
- Laila, A.J.A.; Gamaleldin, I.H.; Fars, K.A. Development of nimesulide analogs as a dual inhibitor targeting tubulin and HSP27 for treatment of female cancers. J. Mol. Struct. 2022, 1248, 131479. [Google Scholar] [CrossRef]
- Laila, A.J.A.; Mayada, S.A. Nimesulide derivatives reduced cell proliferation against breast and ovarian cancer: Synthesis, characterization, biological assessment, and crystal structure. Kuwait J. Sci. 2022, 49, 1–17. [Google Scholar]
- Hugo, V.-V.V.; Alejandro, H.S.M.; María, V.S.A.; María, R.H.; Antonio, L.R.M.; Guadalupe, P.O.M.; Antonio, M.G.M.; Fernando, A.H.; Víctor, A.; Diego, C.A.; et al. Molecular Modeling and Synthesis of Ethyl Benzyl Carbamates as Possible Ixodicide Activity. Comput. Chem. 2018, 7, 1–26. [Google Scholar] [CrossRef]
- Andersson, M.P.; Uvdal, P. New Scale Factors for Harmonic Vibrational Frequencies Using the B3LYP Density Functional Method with the Triple-ζ Basis Set 6-311+G(d,p). J. Phys. Chem. A 2005, 109, 2937–2941. [Google Scholar] [CrossRef]
- Bhat, A.R.; Dongre, R.S.; Almalki, F.A.; Berredjem, M.; Aissaoui, M.; Touzani, R.; Hadda, T.B.; Akhter, M.S. Synthesis, biological activity and POM/DFT/docking analyses of annulated pyrano[2,3-d]pyrimidine derivatives: Identification of antibacterial and antitumor pharmacophore sites. Bioorg. Chem. 2021, 106, 104480. [Google Scholar] [CrossRef]
- Guerfi, M.; Berredjem, M.; Bahadi, R.; Djouad, S.-E.; Bouzina, A.; Aissaoui, M. An efficient synthesis, characterization, DFT study and molecular docking of novel sulfonylcycloureas. J. Mol. Struct. 2021, 1236, 130327. [Google Scholar] [CrossRef]
- Shakdofa, M.M.E.; Morsy, N.A.; Rasras, A.J.; Al-Hakimi, A.N.; Shakdofa, A.M.E. Synthesis, characterization, and density functional theory studies of hydrazone–oxime ligand derived from 2,4,6-trichlorophenyl hydrazine and its metal complexes searching for new antimicrobial drugs. Organomet. Chem. 2020, 32, e3936. [Google Scholar] [CrossRef]
- Mohan, B.; Choudhary, M. Synthesis, crystal structure, computational study and anti-virus effect of mixed ligand copper (II) complex with ONS donor Schiff base and 1, 10-phenanthroline. J. Mol. Struct. 2021, 1246, 131246. [Google Scholar] [CrossRef]
- Andrew, F.P.; Ajibade, P.A. Synthesis, characterization and anticancer studies of bis(1-phenylpiperazine dithiocarbamato) Cu(II), Zn(II) and Pt(II) complexes: Crystal structures of 1-phenylpiperazine dithiocarbamato-S,S′ zinc(II) and Pt(II). J. Mol. Struct. 2018, 1170, 24–29. [Google Scholar] [CrossRef]
- Agnieszka, D.K.; Liliana, M. Structural studies and characterization of 3-formylchromone and products of its reactions with chosen primary aromatic amines. J. Mol. Struct. 2011, 985, 233–242. [Google Scholar] [CrossRef]
- Saif, M.; Hoda, F.E.; Mahmoud, M.; Eid, M.F.; Nabeel, A.I.; Fouad, R. Hydrothermal preparation and physicochemical studies of new copper nano-complexes for antitumor application. J. Mol. Struct. 2018, 1155, 765–775. [Google Scholar] [CrossRef]
- Damena, T.; Alem, M.B.; Zeleke, D.; Desalegn, T.; Eswaramoorthy, R.; Demissie, T.B. Novel Zinc(II) and Copper(II) Complexes of 2-((2-Hydroxyethyl)amino)quinoline-3-carbaldehyde for Antibacterial and Antioxidant Activities: A Combined Experimental, DFT, and Docking Studies. ACS Omega 2022, 7, 26336–26352. [Google Scholar] [CrossRef]



























| Compounds | Color | M.Wt. | Dipole Moment μ | M.P. (°C) | Λa | Calculated/(Found) (%) | ||||
|---|---|---|---|---|---|---|---|---|---|---|
| C | H | N | S | M | ||||||
| Free ligand H2L (C6H12N6S2) | Pale yellow | 232.32 | -- | 225 | -- | 31.02 (31.04) | 5.21 (5.16) | 36.17 (35.07) | 27.60 (27.83) | -- |
| Cu complex [Cu(L)].2H2O (C6H14CuN6O2S2) | Dark brown | 329.89 (293.97) * | 1.249 | 263–270 | 4.34 | 21.84 (21.98) | 4.28 (3.80) | 25.48 (24.33) | 19.44 (18.95) | 20.31 (19.89) |
| Cobalt complex [Co(L)].2H2O (C6H14CoN6O2S2) | Brown | 325.28 (288.97) * | 1.429 | 245–248 | 5.83 | 22.15 (22.22) | 4.34 (4.65) | 25.84 (24.70) | 19.72 (19.68) | 31.60 (31.28) |
| Zinc complex [Zn(H2L)2] (C12H26N12S4Zn) | Beige | 532.06 (535.6) | 1.837 | 268–272 | 21.52 | 27.09 (27.83) | 4.93 (4.95) | 31.59 (31.77) | 24.11 (25.38) | 19.26 (18.95) |
| Position | H2L | [Zn(H2L)2] Diamagnetic | ||
|---|---|---|---|---|
| 1H δ (ppm) | 13C δ (ppm) | 1H δ (ppm) | 13C δ (ppm) | |
| 1 | -- | 148.37 | -- | 148.27 |
| 2 | -- | -- | ||
| 3 | 1.947 | 13.81 | 2.168 | 11.54 |
| 4 | -- | -- | -- | -- |
| 5 | -- | -- | -- | -- |
| 6 | 10.197, 11.061 | -- | 10.208 | -- |
| 7 | -- | -- | ||
| 8 | -- | 183.12 | -- | 178.84 |
| 9 | -- | -- | ||
| 10 | 8.390, 8.101 | -- | 7.850, 8.404 | -- |
| 12 | -- | -- | ||
| 13 | -- | -- | -- | -- |
| 14 | 1.947 | 11.55 | 2.508 | 11.54 |
![]() | ||||
| Compounds | ν(H2O) ν(NH/NH2) cm−1 | ν(C=N) ν(C=N) * cm−1 | ν(C=S) ν(C-S) cm−1 | ν(N-N) cm−1 | ν(M-N) cm−1 | ν(M-S) cm−1 |
|---|---|---|---|---|---|---|
| H2L (C6H12N6S2) | 3408 sbr, 3248 sbr, 3194 sbr, 3149 sbr | 1594 s -- | 833 m -- | 1300 m | -- | -- |
| [Cu(L)].2H2O (C6H14CuN6O2S2) | 3407 sbr, 3250 sbr, 3187 sbr, 3144 sbr | 1595 s, 1648 w | -- 649 w | 1298 m | 603 m | 485 w |
| [Co(L)].2H2O (C6H14CoN6O2S2) | 3407 sbr, 3248 sbr, 3189 sbr, 3148 sbr | 1593 s, 1693 w | -- 948m | 1294 m | 599 m | 484 w |
| [Zn(H2L)2] (C12H26N12S4Zn) | 3408 sbr, 3248 sbr, 3189 sbr, 3151 sbr | 1594 s -- | 831 m -- | 1293 m | 602 w | 483 w |
| Compounds | Temp. (°C) | Weight Loss (%) Found (Calcd.) | Assignment |
|---|---|---|---|
| Free ligand H2L (C6H12N6S2) | 30–191 191–221 230–650 | -- 7.38(6.90) 91.67 (93.10) | Stable Elimination of NH2 Complete decomposition of the ligand |
| Copper complex [Cu(L)].2H2O (C6H14CuN6O2S2) | 73.99 254–776 800 | 11.28 (10.91) 63.58 (62.53) 25.13 (26.54) | - 2H2O - C4H10N6S2 Cu+ 2C (Residue) |
| Cobalt complex [Co(L)].2H2O (C6H14CoN6O2S2) | 70 269–761 800 | 08.51 (11.07) 64.19 (63.41) 27.22 (25.50) | - 2H2O - C4H10N6S2 Co+ 2C (Residue) |
| Zinc complex [Zn(H2L)2] (C12H26N12S4Zn) | 30–157 265–750 800 | -- 73.83 (75.56) 26.17 (24.34) | Stable - C12H26N12S2 Zn+2S (Residue) |
| Mag. | Co–Ligand Complex | Cu–Ligand Complex | Zn–Ligand Complex |
|---|---|---|---|
| ×100 | ![]() | ![]() | ![]() |
| ×500 | ![]() | ![]() | ![]() |
| ×1000 | ![]() | ![]() | ![]() |
| ×2000 | ![]() | ![]() | ![]() |
| ×5000 | ![]() | ![]() | ![]() |
| Metal Complex | Particle Size ± Standard Deviation (d.nm) | Graph | ![]() |
| Co–ligand complex | 266.7 ± 83.31 | ![]() | |
| Cu–ligand complex | 226.9 ± 75.18 | ![]() | |
| Zn–ligand complex | 254.9 ± 68.87 | ![]() |
| Parameter | Dilution Used to Treat the Cells with the Metal Complexes/µg | ||||
|---|---|---|---|---|---|
![]() | |||||
| Co–ligand complex 1:1 | ![]() ![]() | ||||
| Drug conc µg | 0 | 2.5 | 5 | 10 | 20 |
| Mean—blank | 100 | 69.2 | 68.4 | 63.6 | 48.1 |
| Standard deviation | 8.00 | 7.15 | 7.08 | 8.29 | 3.07 |
| HEK293 | - | - | - | - | 80.50 ± 3.139 |
| Cu–ligand complex 1:1 | ![]() ![]() | ||||
| Drug conc µg | 0 | 2.5 | 5 | 10 | 20 |
| Mean—blank | 100 | 9.80 | 6.06 | 3.91 | 3.31 |
| Standard deviation | 7.97 | 1.58 | 0.34 | 0.44 | 0.34 |
| HEK293 | - | - | - | - | 66.66 ± 4.586 |
| Zn–ligand complex 2:1 | ![]() ![]() | ||||
| Drug conc µg | 0 | 2.5 | 5 | 10 | 20 |
| Mean—blank | 100 | 67.1 | 55.7 | 45.2 | 32.1 |
| Standard deviation | 2.45 | 0.92 | 6.14 | 3.17 | 4.80 |
| HEK293 | - | - | - | - | 67.77 ± 5.875 |
| ID | Etotal (Hartree) | E * HOMO | ELUMO | ΔE | I = −E HOMO | A = −E LUMO | H = (EHOMO − ELUMO)\2 | S = 1\η | µ = −(1 + A)\2 | X = (I + A)/2 |
|---|---|---|---|---|---|---|---|---|---|---|
| Co-L complex | −1175.560 | −5.667 | −1.498 | 4.169 | 5.667 | 1.498 | −2.084 | −0.480 | −1.249 | 3.582 |
| Cu-L complex | −1918.132 | −4.335 | −1.858 | 2.478 | 4.335 | 1.858 | −1.239 | −0.807 | −1.429 | 3.097 |
| Zn-L complex | −1762.038 | −5.668 | −2.674 | 2.995 | 5.668 | 2.674 | −1.497 | −0.668 | −1.837 | 4.171 |
| Strain/Concentration | 5 mg | 10 mg | ![]() |
| Bacillus subtills (Gram positive) | Inhibition zone mm | ||
| Co-L complex | 9 | 9.3 | |
| Cu-L complex | 12.3 | 14 | |
| Zn-L Complex | Nill | Nill | |
| Free ligand | Nill | Nill | |
| Strain/concentration | 5 mg | 10 mg | |
| E. coli (Gram negative) | inhibition zone mm | ||
| Co-L complex | Nill | Nill | |
| Cu-L complex | 5.6 | 6 | |
| Zn-L Complex | Nill | Nill | |
| Free ligand | Nill | Nill | |
![]() | |||
Disclaimer/Publisher’s Note: The statements, opinions and data contained in all publications are solely those of the individual author(s) and contributor(s) and not of MDPI and/or the editor(s). MDPI and/or the editor(s) disclaim responsibility for any injury to people or property resulting from any ideas, methods, instructions or products referred to in the content. |
© 2025 by the authors. Licensee MDPI, Basel, Switzerland. This article is an open access article distributed under the terms and conditions of the Creative Commons Attribution (CC BY) license (https://creativecommons.org/licenses/by/4.0/).
Share and Cite
Alshehab, A.; Haider, A.; Jaragh-Alhadad, L. Significance of Nano Transition Metal Complexes as Anticancer and Antibacterial Therapeutic Agents. Int. J. Mol. Sci. 2025, 26, 10516. https://doi.org/10.3390/ijms262110516
Alshehab A, Haider A, Jaragh-Alhadad L. Significance of Nano Transition Metal Complexes as Anticancer and Antibacterial Therapeutic Agents. International Journal of Molecular Sciences. 2025; 26(21):10516. https://doi.org/10.3390/ijms262110516
Chicago/Turabian StyleAlshehab, Abdulaziz, Ameena Haider, and Laila Jaragh-Alhadad. 2025. "Significance of Nano Transition Metal Complexes as Anticancer and Antibacterial Therapeutic Agents" International Journal of Molecular Sciences 26, no. 21: 10516. https://doi.org/10.3390/ijms262110516
APA StyleAlshehab, A., Haider, A., & Jaragh-Alhadad, L. (2025). Significance of Nano Transition Metal Complexes as Anticancer and Antibacterial Therapeutic Agents. International Journal of Molecular Sciences, 26(21), 10516. https://doi.org/10.3390/ijms262110516